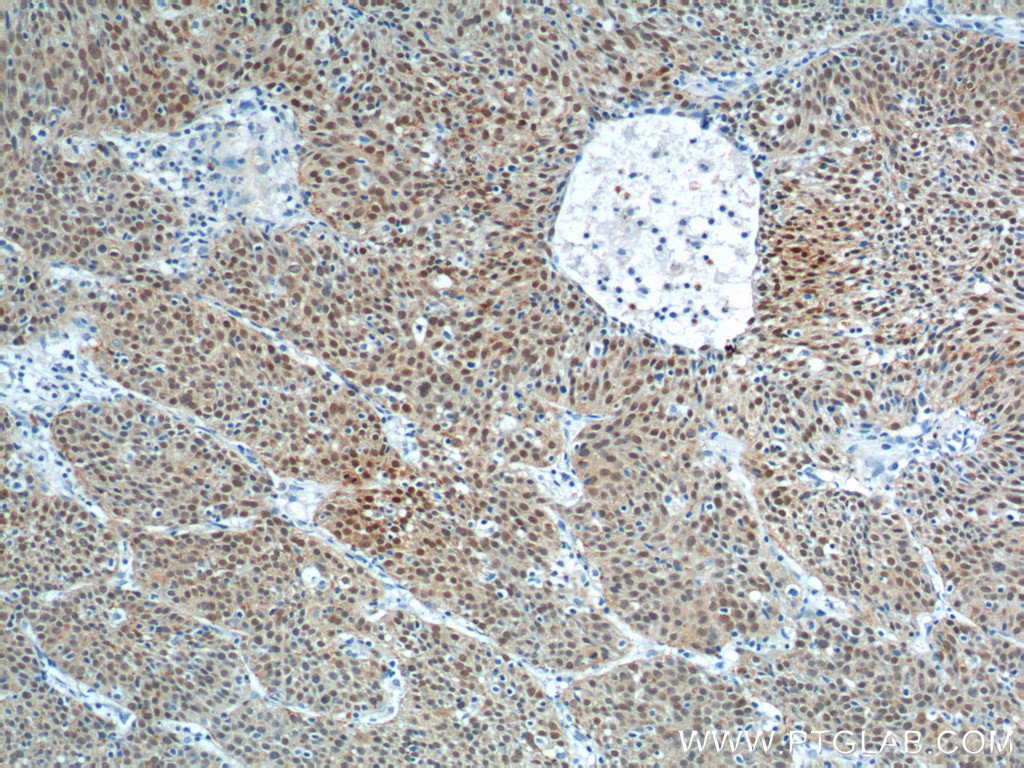

验证数据展示
经过测试的应用
| Positive WB detected in | HEK-293 cells |
| Positive IHC detected in | human lung cancer tissue, human cervical squamous cancer tissue, human gliomas tissue, mouse brain tissue, mouse embryo tissue Note: suggested antigen retrieval with TE buffer pH 9.0; (*) Alternatively, antigen retrieval may be performed with citrate buffer pH 6.0 |
| Positive IF-P detected in | human embronic stem cells, mouse embryo tissue, mouse brain tissue |
推荐稀释比
| 应用 | 推荐稀释比 |
|---|---|
| Western Blot (WB) | WB : 1:500-1:1000 |
| Immunohistochemistry (IHC) | IHC : 1:50-1:200 |
| Immunofluorescence (IF)-P | IF-P : 1:10-1:100 |
| It is recommended that this reagent should be titrated in each testing system to obtain optimal results. | |
| Sample-dependent, Check data in validation data gallery. | |
产品信息
11064-1-AP targets SOX2 in WB, IHC, IF-P, IP, CoIP, ELISA applications and shows reactivity with human, mouse, rat, zebrafish samples.
| 经测试应用 | WB, IHC, IF-P, ELISA Application Description |
| 文献引用应用 | WB, IHC, IF, IP, CoIP |
| 经测试反应性 | human, mouse, rat, zebrafish |
| 文献引用反应性 | human, mouse, rat, pig, hamster, goat |
| 免疫原 |
CatNo: Ag1530 Product name: Recombinant human SOX2 protein Source: e coli.-derived, PGEX-4T Tag: GST Domain: 59-118 aa of BC013923 Sequence: MAQENPKMHNSEISKRLGAEWKLLSETEKRPFIDEAKRLRALHMKEHPDYKYRPRRKTKT 种属同源性预测 |
| 宿主/亚型 | Rabbit / IgG |
| 抗体类别 | Polyclonal |
| 产品类型 | Antibody |
| 全称 | SRY (sex determining region Y)-box 2 |
| 别名 | ANOP3, MCOPS 3, MCOPS3, SOX 2, Transcription factor SOX 2 |
| 计算分子量 | 34 kDa |
| 观测分子量 | 34-40 kDa |
| GenBank蛋白编号 | BC013923 |
| 基因名称 | SOX2 |
| Gene ID (NCBI) | 6657 |
| RRID | AB_2195801 |
| 偶联类型 | Unconjugated |
| 形式 | Liquid |
| 纯化方式 | Antigen affinity purification |
| UNIPROT ID | P48431 |
| 储存缓冲液 | PBS with 0.02% sodium azide and 50% glycerol, pH 7.3. |
| 储存条件 | Store at -20°C. Stable for one year after shipment. Aliquoting is unnecessary for -20oC storage. |
背景介绍
Background
SRY (sex determining region Y)-box 2 is a transcription factor involved in neural stem cell maintenance and has been used in somatic cell reprogramming.
What is the molecular weight of Sox2?
34 kDa. Sox2 is an intronless gene encoding xx amino acids including HMG (High-mobility group) box domains that can bind to DNA.
What is the tissue specificity of Sox2?
In embryonic stem cells, Sox2 is highly expressed and is essential in self-renewal. In the developing embryo, Sox2 is found in the neural tube and then in the developing eye and central nervous system (CNS). This expression is highly conserved across organisms (PMID: 25126380; PMID: 8625802).
In adult tissues Sox2 is expressed in neural progenitor cells, which as multipotent cells can both self-renew and differentiate into neurons, astroglia, and oligodendroglia. It maintains their stem cell phenotype and is a useful marker of early neural stem cells (PMID: 16139372).
What is the role of Sox2 in pluripotency?
Sox2 acts as part of the LIF (Leukemia inhibitory factor) pathway, activated via JAK-STAT signaling to form complexes with other transcription factors such as Oct4 that bind to DNA and work to control pluripotency. Sox2 was described as one of the four original factors that are key to the reprogramming of somatic cells to induced pluripotent stem cells (iPSCs) (PMID: 16904174).
What is the role of Sox2 in cancer?
The ability to control pluripotency means dysregulation of Sox2 can lead to uncontrolled proliferation. In many different cancers, Sox2 has been associated with the metastasis and growth of tumors, mostly due to overexpression (PMID: 28388544). The increased levels of Sox2 RNA and protein in tumor tissue highlight it as a potential therapeutic target (PMID: 25114775).
实验方案
| Product Specific Protocols | |
|---|---|
| IF protocol for SOX2 antibody 11064-1-AP | Download protocol |
| IHC protocol for SOX2 antibody 11064-1-AP | Download protocol |
| WB protocol for SOX2 antibody 11064-1-AP | Download protocol |
| Standard Protocols | |
|---|---|
| Click here to view our Standard Protocols |
发表文章
| Species | Application | Title |
|---|---|---|
Cell Stem Cell The long noncoding RNA lncTCF7 promotes self-renewal of human liver cancer stem cells through activation of Wnt signaling. | ||
Cell Stem Cell Injury Induces Endogenous Reprogramming and Dedifferentiation of Neuronal Progenitors to Multipotency. | ||
Nat Struct Mol Biol TDP-43 aggregation induced by oxidative stress causes global mitochondrial imbalance in ALS. | ||
Neuron UBQLN2-HSP70 axis reduces poly-Gly-Ala aggregates and alleviates behavioral defects in the C9ORF72 animal model. | ||
Mol Psychiatry Pharmacological enhancement of mGlu5 receptors rescues behavioral deficits in SHANK3 knock-out mice. | ||
Nat Commun TSPAN8 promotes cancer cell stemness via activation of sonic Hedgehog signaling. |